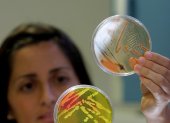

Actualidad
Una fiesta sin horario
Redacción Expresiones
Por su aniversario 198 de independencia, Guayaquil ofrece una variada programación de eventos. Hay bailes, ferias y delicias gastronómicas.

Actualidad
Redacción Expresiones
Por su aniversario 198 de independencia, Guayaquil ofrece una variada programación de eventos. Hay bailes, ferias y delicias gastronómicas.

Actualidad
Redacción Expresiones
Algunos órganos del cuerpo no funcionan bien sin los microbios necesarios.

Actualidad
Redacción Expresiones
El Gobierno central todavía tiene fondos disponibles de los asignados para el terremoto. La Contraloría revisa las cifras.






Más visto